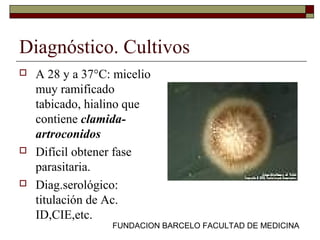
FUNDACION BARCELO FACULTAD DE MEDICINA
Diagnóstico. Cultivos
 A 28 y a 37°C: micelio
muy ramificado
tabicado, hialino que
contiene clamida-
artroconidos
 Difícil obtener fase
parasitaria.
 Diag.serológico:
titulación de Ac.
ID,CIE,etc.

El documento aborda las micosis sistémicas endémicas causadas por hongos dimórficos como Histoplasma capsulatum, Coccidioides immitis y Paracoccidioides brasiliensis, describiendo su epidemiología, diagnóstico y tratamiento. Se destaca la forma de infección, que suele ser inhalatoria, y los distintos tipos de enfermedades que pueden surgir, así como los factores predisponentes. También se menciona la importancia del diagnóstico clínico y micológico para el manejo adecuado de estas infecciones.